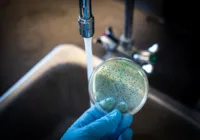
Brasil confirma caso autóctone de cólera em Salvador

MUNDO
Surto mortal de cólera se espalha em meio à guerra e chuva intensa
Organizações alertam para crise humanitária agravada pela escassez de água potável
SALVADOR
Brasil confirma caso autóctone de cólera em Salvador
Últimos casos autóctones ocorreram em Pernambuco em 2004 e 2005
Mais Lidas

BAHIA
Festival Vermelho: Ato internacional reforça apoio à Palestina

ENTRETENIMENTO
Helen Ganzarolli revela queixa de fotógrafo da Playboy: Parece virgem

ESPORTES
Clube tradicional da Série B é processado por padaria por pães

IMOBILIÁRIO
Juros altos travam sonho da casa própria

 OUÇA A RÁDIO
OUÇA A RÁDIO
